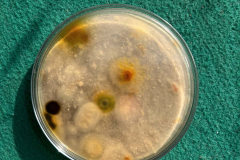
3

U okviru interdisciplinarnog projekta Bioart, učenici druge godine Savremene gimnazije istraživali su svet mikroorganizama skrivenih u svakodnevnim predmetima i svoja zapažanja pretočili u vizuelne radove, spajajući nauku i umetnost na nesvakidašnji način.

Projekat je nastao kroz saradnju profesorke hemije Jelene Zelenović i profesorke umetnosti i dizajna Zorane Milićević, a njegov cilj bio je da učenici povežu laboratorijsko istraživanje sa estetskim izražajem. Tokom višenedeljne aktivnosti, učenici su uzimali briseve sa različitih površina — uključujući, između ostalog, i popularne Poterijeve šolje — koje su potom postavljali na hranljive podloge, prateći razvoj bakterijskih i gljivičnih kolonija.
Kada su mikroorganizmi „naslikali“ svoja apstraktna dela unutar Petrijevih šolja, učenici su ih fotografisali i analizirali, istražujući kako se biološki procesi mogu interpretirati kroz vizuelnu estetiku. Tako su nastali radovi koji predstavljaju spoj naučne radoznalosti i umetničke imaginacije, otkrivajući nevidljivi svet koji nas svakodnevno okružuje — i lepotu tamo gde je često ne očekujemo.
Kroz projekat su učenici razvijali analitičko mišljenje, eksperimentalne veštine i osećaj za umetničku kompoziciju. Bioart je još jedan primer kako interdisciplinarni pristupi mogu obogatiti proces učenja, produbiti razumevanje i podstaći nova pitanja o granicama nauke, umetnosti i etike.